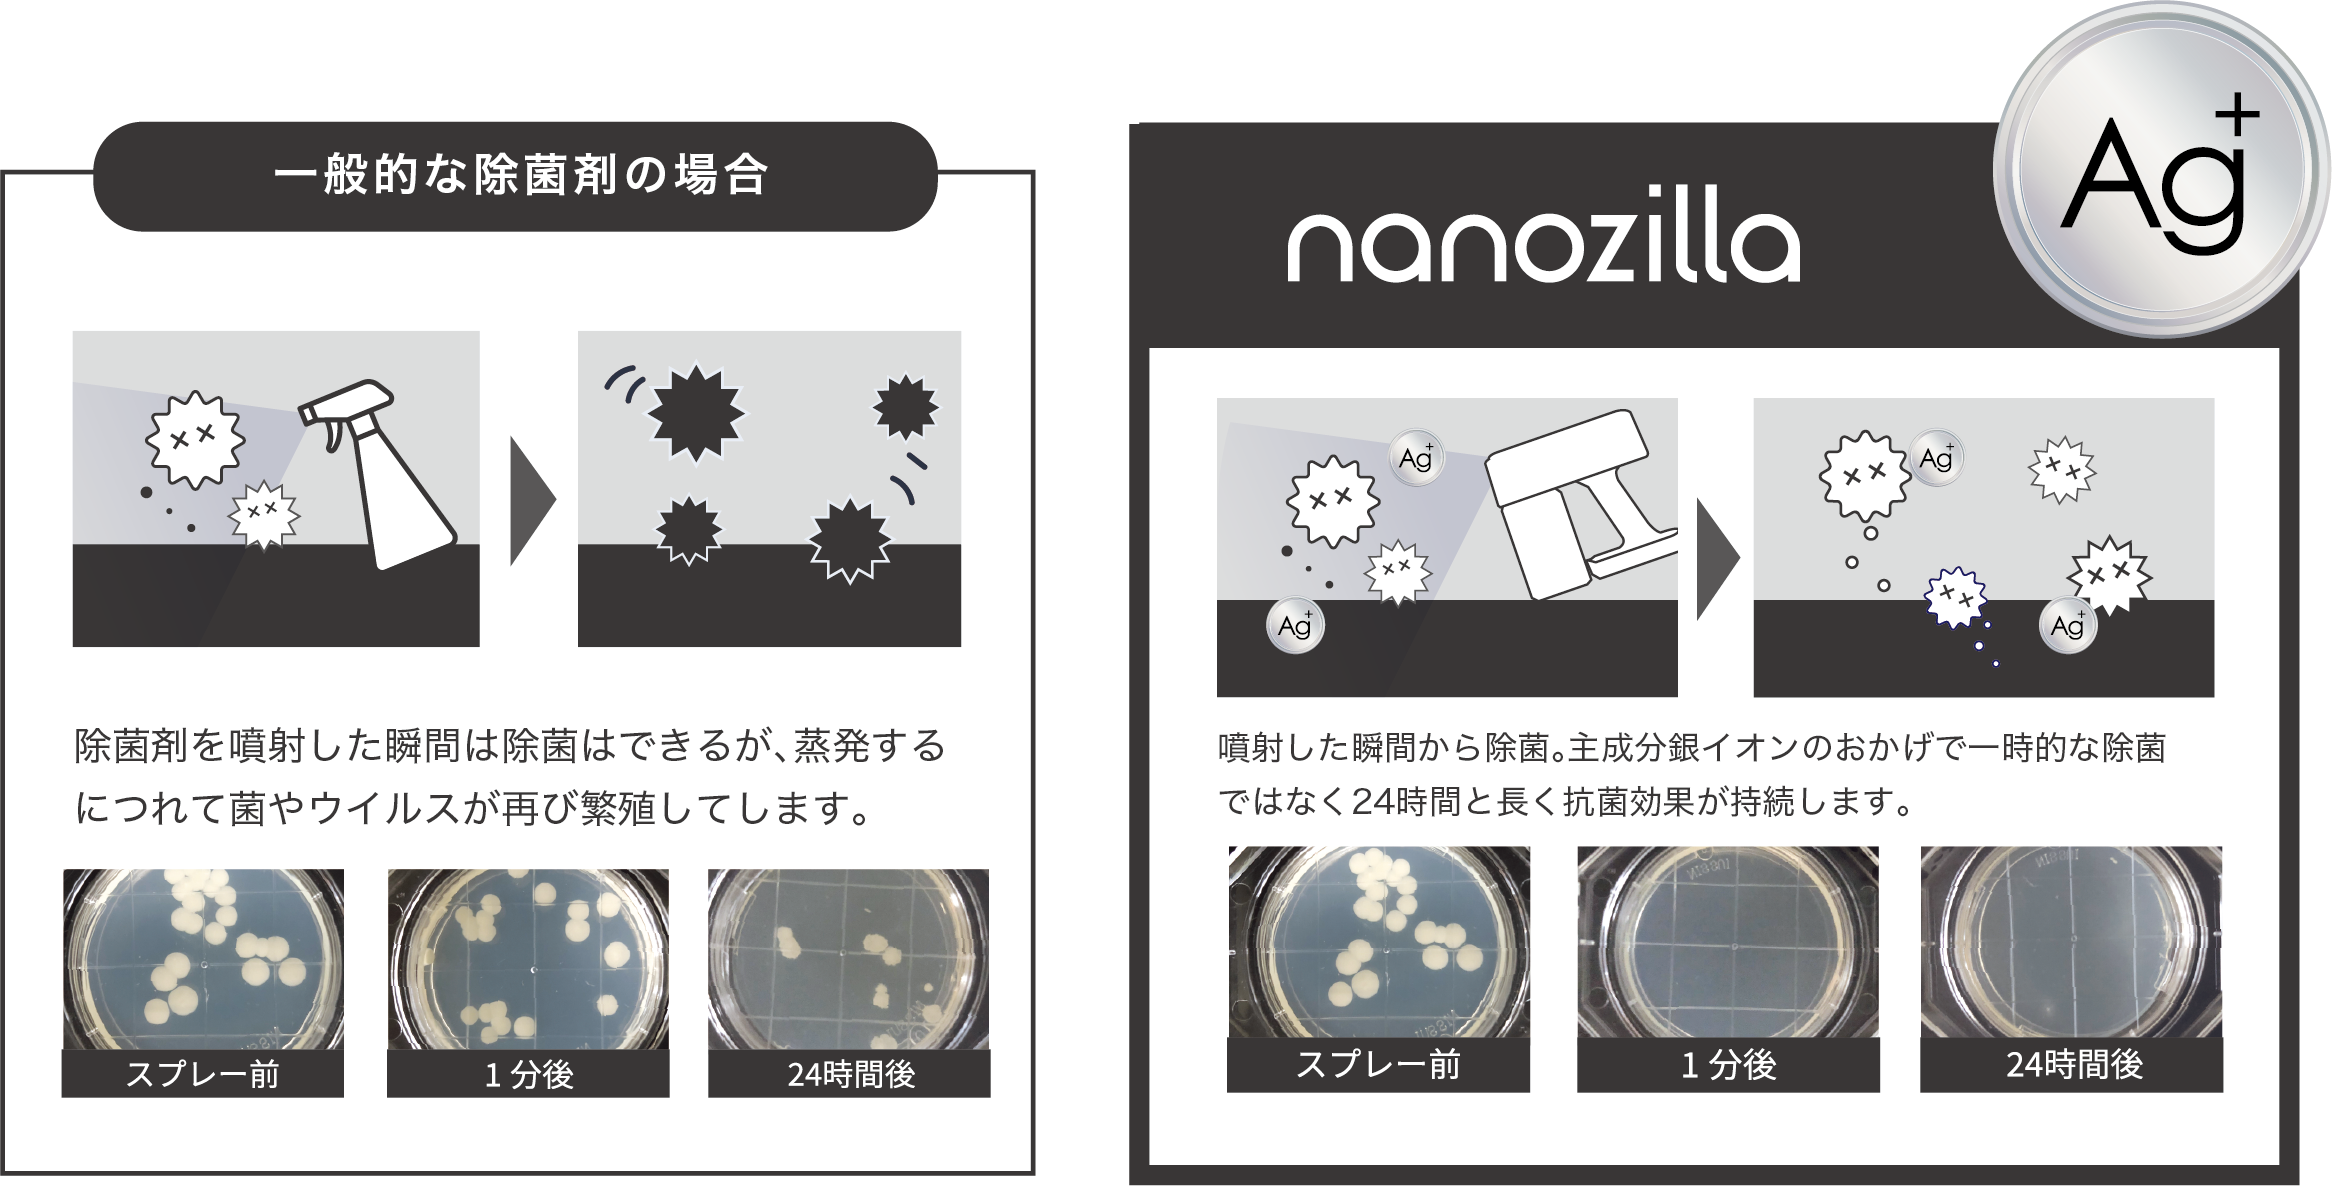

様々な感染症対策に、これまでにない除菌・抗菌 新方式プロダクト
抗菌事業を主体とした歯科に関する商品の製造販売を行う株式会社ピカッシュ(本社:熊本県菊池郡)が「ナノ・ジーラ」を販売。インテリアに調和する洗練されたデザインになっており、生活感を感じさせないプロダクト。イメージモデルはエディトリアル、ショー等で活動中のクレオ由貴を起用。


ナノ・ジーラはミスト状の銀イオン水を噴霧することでお手軽に99.9%除菌&24時間抗菌、噴霧と噴射ができる 2WAY タイプの新方式プロダクトです。

ナノ・ジーラが開発された背景

歯科関連商品の製造・販売を行う株式会社ピカッシュが、歯科医療器具などを管理する際の細菌増殖を防ぐ方法を模索していく中で、銀イオンを活用した除菌スプレーを特許技術として開発。新型コロナウイルスの出現により歯科医療現場からのニーズもあり、さらに開発を重ねました。
歯科医療の院内でウイルスや細菌から守るために使われていたものを一般向けに商品化。様々な施設や企業はもちろん一般のご家庭でもより使いやすくより効果的な商品へとブラッシュアップされたものが、このナノ・ジーラです。
99.9%除菌、24 時間持続的に抗菌

ナノ・ジーラ は専用の銀イオン除菌液と組み合わせることで効果を発揮します。細菌やウイルスに対し、99.9%除菌、1日1回で24時間抗菌効果(※1)が持続します。
銀イオンを主成分とした専用除菌液は感染症対策、カビ対策、消臭対策として様々なシーンに活用いただけます。
※1 本結果は一定の条件下で行われた試験結果であり、使用状況により効果が異なる場合がございます。
※全ての菌・ウィルスに効果があるわけではありません。
拭き取りがいらず1日1回の噴霧で24時間効果(※1)が持続するため、時間がかかっていた感染対策も大幅に簡素化。
そのため企業・店舗では従業員の作業時間を短縮&人件費の削減が可能に。


コロナウイルスが2類から5類に移行した現在だからこそ、重症化しやすい基礎疾患のある方や高齢者をどう守るか、感染拡大を防ぐなど様々な課題も残り、マスクの装着が個人の自由になった今だからこそ正しい感染対策が求められます。
ナノ・ジーラの機能性について

寝室やリビングなどに置いておくだけで、ひと部屋 60〜90分でミストが部屋全体に行き渡り、手の届きにくいところまで除菌・抗菌する「噴霧モード」。ドアノブや衣服・小物、お子さまのおもちゃなど部分的に除菌・抗菌したい時には、拭き取り不要の「噴射モード」。
この 2 つのモードを使い分けて、シーンに合わせた除菌・抗菌対策が可能です。
また、USB充電式で持ち運びが楽。消臭効果もあるため、車や衣服、ペット用品の使用にもおすすめです。またボトルは簡単に取り外すことができ、水洗いが可能なので清潔な状態で繰り返し使用できます。
ナノ・ジーラの導入事例

医療現場や介護施設などで使用されている他、店舗や教育現場、空港などでも導入・活用されています。これらの安全性が重要な施設で導入される理由は、除菌液の主成分である銀イオンにあります。
一般的に広く使われているアルコール除菌液は一時的な除菌には優れておりますが蒸発してしまうと効果がなくなってしまいます。しかし銀イオンは24 時間抗菌効果が持続するという大きな違いがあります。
これまで手作業で時間がかかっていた感染対策も大幅に簡素化できるため企業・店舗では従業員の作業時間を短縮でき人件費の削減、ご家庭では家事の時間を短縮。 24時間抗菌効果が持続し1日1回の噴霧で済むため「感染症対策が楽になった」とたくさんの方からお声をいただきます。無香料ノンアルコールなので、お肌が弱い方や小さなお子さまのいる環境でも安心して使用することができます。
ナノ・ジーラでは
正規代理店パートナーを募集しております
さまざまな企業・店舗・ご家庭で導入いただいております。より多くの皆さまにナノ・ジーラの良さを知っていただけるよう、株式会社ピカッシュでは代理店制度を設けております。安心できるパートナシップを結び、同じ想いを持って共に発展していける代理店様を募集しています。詳しくはナノ・ジーラブランドサイトをご覧ください。

商号:株式会社ピカッシュ
所在地:熊本県菊池郡菊陽町原水2849-1
代表者:高橋 昌平
創業:2013年8月
事業内容:歯科に関する商品の製造販売
公式サイト:https://pikasshu.jp/
製品情報
製品名:nanozilla(ナノ・ジーラ)
公式ブランドサイト:https://nanozilla.net/
すべての画像
- 種類
- 商品サービス
- ビジネスカテゴリ
- フィットネス・ヘルスケア日用品・生活雑貨
- ダウンロード